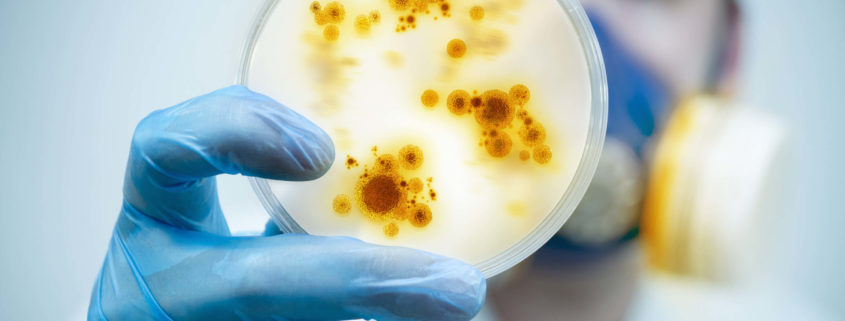

We got the tools
Die DKH verfügt über die notwendigen Messinstrumente um alle Messungen nach den jeweiligen EN,DIN und VDI Verordnungen und Richtlinien bestimmungsgemäß durchführen zu können.
Alle Messinstrumente sind regelmässig gewartet und kalibriert.